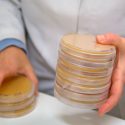

diversidad
-

Las plagas impulsan la diversidad en las selvas tropicales
Un estudio de biólogos de la Universidad de Utah revela que las plagas y las defensas de las plantas contra los invasores impulsan la diversidad…
-

Descubierta la cuna del chocolate en el Amazonas: 1,500 años antes de lo que se creía
La historia del chocolate se ha reescrito. Los primeros en cultivar el árbol del cacao no fueron los pueblos de Centroamérica hace 3.900 años, como…
-

La alimentación humana no sostenible amenaza cultivos silvestres y delfines
La última actualización de la Lista Roja de Especies Amenazadas de la Unión Internacional para la Conservación de la Naturaleza (UICN) revela que varias especies…
-

Google despide al autor del polémico manifiesto sobre diversidad por «perpetuar estereotipos de género»
La polémica generada por la carta de un empleado de Google en contra a las políticas de diversidad de la compañía está lejos de terminar.…